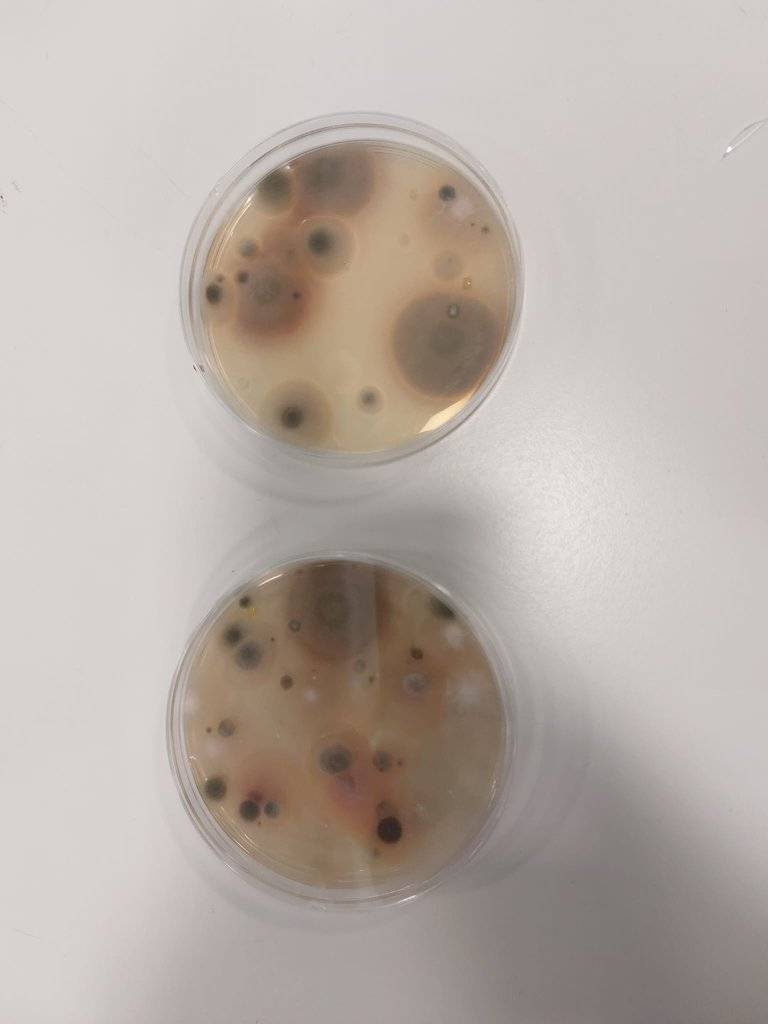

Uczniowie kl. 4gż mieli wyjątkową okazję uczestniczyć w zajęciach na Uniwersytecie Przyrodniczym w Poznaniu. Spotkanie odbyło się w Katedrze Biotechnologii i Mikrobiologii Żywności, gdzie młodzież wzięła udział w wykładzie teoretycznym, a następnie w praktycznych warsztatach laboratoryjnych.
Podczas zajęć uczniowie samodzielnie przygotowywali preparaty mikroskopowe, sporządzali wymazy oraz dokonywali ich oceny pod mikroskopem. Była to nie tylko cenna lekcja biologii i mikrobiologii, ale także fascynujące doświadczenie, które pozwoliło uczestnikom poczuć się jak prawdziwi naukowcy.
Dziękujemy Uniwersytetowi Przyrodniczemu za gościnność i inspirujące zajęcia! Takie spotkania pokazują, jak ważne jest łączenie teorii z praktyką oraz rozwijanie pasji i zainteresowań uczniów.